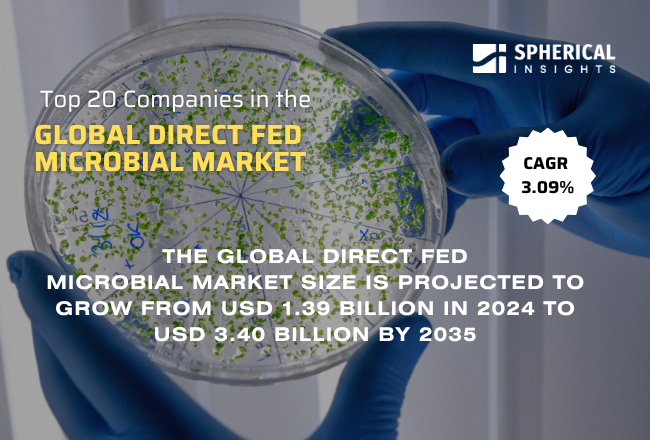
Global Direct Fed Microbial Market

Top 20 Companies in the Global Direct Fed Microbial Market 2025: Strategic Overview and Future Trends (2024–2035)
RELEASE DATE: Mar 2026 Author: Spherical InsightsRequest Free Sample Speak to Analyst
Introduction
The global Direct-fed microbials (DFM) function as living microorganisms which include bacteria and yeast that animal feed to support gut health and nutrient uptake and improve animal performance. The products are obtained from natural materials which include lactic acid bacteria Bacillus strains yeast cultures and fermentation substrates. The agricultural sector utilizes DFMs to enhance digestion and boost immunity and improve feed efficiency while decreasing disease risks in livestock and poultry and swine and aquatic animals. The market demonstrates three main trends which include increasing demand for feed additives without antibiotics and rising interest in animal welfare and developments in microbial technology. The market presents new opportunities through innovative strain development and growing applications in aquaculture and precision agriculture. The global adoption of DFMs receives support through government initiatives which include banning antibiotic growth promoters and promoting sustainable agriculture and through regulatory guidelines which ensure safe feed additive use.
Navigate Future Markets with Confidence: Insights from Spherical Insights LLP
The insights presented in this blog are derived from comprehensive market research conducted by Spherical Insights LLP, a trusted advisory partner to leading global enterprises. Backed by in-depth data analysis, expert forecasting, and industry-specific intelligence, our reports empower decision-makers to identify strategic growth opportunities in fast-evolving sectors. Clients seeking detailed market segmentation, competitive landscapes, regional outlooks, and future investment trends will find immense value in the full report. By leveraging our research, businesses can make informed decisions, gain a competitive edge, and stay ahead in the transition toward sustainable and profitable solutions.
Unlock exclusive market insights—Download the Brochure now and dive deeper into the future of the Direct Fed Microbial Market.
Market Segmentation
Global Direct Fed Microbial Market Size, Share, By Type (Lactic Acid Bacteria, Bacillus subtilis, Yeast, and Others), By Livestock (Ruminants, Poultry, Swine and others), By Form (Dry and Liquid), and By Region (North America, Europe, Asia-Pacific, Latin America, Middle East, and Africa), Analysis and Forecast 2025 - 2035
Direct Fed Microbial Market Size & Statistics
- The Market Size for Direct Fed Microbial Was estimated to be worth USD 1.39 Billion in 2024.
- The Market is going to Expand at a CAGR of 3.09% between 2025 and 2035.
- The Direct Fed Microbial Market Size is anticipated to reach USD 3.40 Billion by 2035.
- North America is expected to generate the highest demand during the forecast period in the Direct Fed Microbial Market
- Asia Pacific is expected to grow the fastest during the forecast period in the Direct Fed Microbial Market.

Regional growth and demand
Asia Pacific is expected to grow the fastest during the forecast period in the Direct Fed Microbial market. Asia Pacific is expected to grow fastest due to rising livestock production, increasing demand for high-quality animal protein, growing awareness of antibiotic-free feed, expanding aquaculture industry, and supportive government initiatives promoting sustainable and efficient animal farming practices.
North America is expected to generate the highest demand during the forecast period in the Direct Fed Microbial market. North America is expected to generate the highest demand due to high advanced animal nutrition practices, high awareness of antibiotic-free feed additives, a well-established livestock industry, and supportive regulations promoting sustainable and efficient animal production.
Ready to lead the Direct Fed Microbial Market ?
Discover the regional trends and growth factors shaping the industry. We’re here to assist with expert, personalized data.
Call +1 303 800 4326 or Send us a message for a personalized consultation.
Top 10 Trends in the Direct Fed Microbial Market
- Antibiotic-free feed demand
- Focus on gut health
- Sustainable livestock farming
- Growth in aquaculture use
- Advanced microbial strains
- Precision farming adoption
- Multi-strain solutions
- Supportive regulations
- Rising protein demand
- Digital animal health management
- Rising Demand for Antibiotic-Free Feed
Increasing restrictions on antibiotic growth promoters and consumer preference for safe, residue-free meat are driving the adoption of direct-fed microbials as natural alternatives to maintain animal health and productivity.
- Focus on Gut Health and Immunity
Producers are emphasizing animal gut health to improve digestion, nutrient absorption, and disease resistance, leading to higher demand for microbial solutions that enhance immunity and overall livestock performance.
- Sustainable Livestock Farming
Growing environmental concerns and the need for efficient resource utilization are promoting sustainable farming practices, where direct-fed microbials help reduce waste, improve feed efficiency, and lower environmental impact.
- Expansion in Aquaculture Applications
Rapid growth of the aquaculture industry is increasing the use of direct-fed microbials to improve water quality, enhance feed conversion, and boost disease resistance in fish and shrimp farming systems.
- Advancements in Microbial Technology
Continuous innovation in microbial strain development, fermentation processes, and product formulations is enabling more effective, species-specific solutions, improving stability, performance, and adoption across diverse livestock sectors.
Empower your strategic planning:
Stay informed with the latest industry insights and market trends to identify new opportunities and drive growth in the Direct Fed Microbial market. To explore more in-depth trends, insights, and forecasts, please refer to our detailed report.
Unlock exclusive market insights—Download the Brochure now and dive deeper into the future of the Direct Fed Microbial Market.
Top 20 Companies Leading the Direct Fed Microbial Market
- Chr. Hansen Holding A/S
- Lallemand Inc.
- Novozymes A/S
- Kemin Industries, Inc.
- Archer Daniels Midland Company (ADM)
- DuPont de Nemours, Inc.
- Koninklijke DSM N.V.
- Lesaffre et Compagnie
- Bio-Vet, Inc.
- Calpis Co., Ltd.
- BASF SE
- Cargill, Incorporated
- Alltech, Inc.
- Novus International, Inc.
- BIOMIN Holding GmbH
- Bayer AG
- American Biosystems, Inc.
- The Fertrell Company
- Adisseo
- Evonik Industries AG
- Chr. Hansen Holding A/S
Headquarters: Horsholm, Denmark.
Chr. Hansen reported approximately USD 1.8 billion revenue in 2025. The company is a global bioscience leader specializing in microbial solutions for food, health, and agriculture. It offers advanced probiotic and microbial feed solutions to enhance animal gut health, productivity, and sustainability, supported by strong R&D and global distribution networks.
- Lallemand Inc.
Headquarters: Montreal, Canada.
Lallemand generated an estimated USD 2.2 billion revenue in 2025. The company focuses on yeast, bacteria, and fermentation-based solutions for animal nutrition. Its direct-fed microbial products improve digestion, immunity, and performance across livestock and aquaculture, backed by extensive research and global technical expertise.
- Novozymes A/S
Headquarters: Bagsværd, Denmark.
Novozymes reported around USD 2.7 billion revenue in 2025. A global leader in biological solutions, the company develops enzymes and microbial technologies for agriculture. Its innovative feed solutions enhance nutrient utilization and animal health while promoting sustainable farming practices and reducing environmental impact.
- Kemin Industries, Inc.
Headquarters: Des Moines, Iowa,
USA. Kemin recorded approximately USD 1.1 billion revenue in 2025. The company provides specialty ingredients, including probiotics and feed additives, for animal nutrition. Its direct-fed microbial solutions support gut health, feed efficiency, and disease resistance, with a strong focus on innovation and safety standards.
- Archer Daniels Midland Company (ADM)
Headquarters: Chicago, Illinois, USA.
ADM reported revenue exceeding USD 95 billion in 2025. The company is a global leader in nutrition and agricultural processing, offering a wide range of feed additives, including microbial solutions, to improve animal performance, sustainability, and feed efficiency across global livestock industries.
Are you ready to discover more about the Direct Fed Microbial market?
The report provides an in-depth analysis of the leading companies operating in the Direct Fed Microbial market. It includes a comparative assessment based on their product portfolios, business overviews, geographical footprint, strategic initiatives, market segment share, and SWOT analysis. Each company is profiled using a standardized format that includes:
Unlock exclusive market insights—Download the Brochure now and dive deeper into the future of the Direct Fed Microbial Market.
Company Profile
- Chr. Hansen Holding A/S
- Business Overview
- Company Snapshot
- Products Overview
- Company Market Share Analysis
- Company Coverage Portfolio
- Financial Analysis
- Recent Developments
- Merger and Acquisitions
- SWOT Analysis
- Lallemand Inc.
- Novozymes A/S
- Kemin Industries, Inc.
- Archer Daniels Midland Company (ADM)
- DuPont de Nemours, Inc.
- Koninklijke DSM N.V.
- Lesaffre et Compagnie
- Bio-Vet, Inc.
- Others.
Conclusion
The global direct-fed microbial market is poised for steady growth, driven by increasing demand for sustainable and antibiotic-free animal nutrition solutions. Rising awareness of gut health, improved livestock productivity, and expanding applications across poultry, swine, and aquaculture sectors are key growth contributors. Technological advancements in microbial strains and supportive regulatory frameworks further strengthen market expansion. While North America leads in demand due to advanced farming practices, Asia-Pacific is emerging as the fastest-growing region supported by rapid livestock production and government initiatives. Leading companies are focusing on innovation, strategic partnerships, and portfolio expansion to maintain competitive advantage.
Our Report
https://www.sphericalinsights.com/reports/japan-fresh-fruits-market
https://www.sphericalinsights.com/reports/italy-contraceptive-devices-market
https://www.sphericalinsights.com/reports/italy-cybersecurity-market
https://www.sphericalinsights.com/reports/italy-beauty-and-personal-care-market
About the Spherical Insights & Consulting
Spherical Insights & Consulting is a market research and consulting firm which provides actionable market research study, quantitative forecasting and trends analysis provides forward-looking insight especially designed for decision makers and aids ROI.
Which is catering to different industry such as financial sectors, industrial sectors, government organizations, universities, non-profits and corporations. The company's mission is to work with businesses to achieve business objectives and maintain strategic improvements.
CONTACT US:
For More Information on Your Target Market, Please Contact Us Below:
Phone: +1 303 800 4326 (the U.S.)
Phone: +91 90289 24100 (APAC)
Email: inquiry@sphericalinsights.com, sales@sphericalinsights.com
Contact Us: https://www.sphericalinsights.com/contact-us
Need help to buy this report?